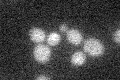
YBR024W
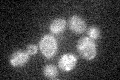
YBR024W

View description
Protein anchored to the mitochondrial inner membrane, similar to Sco1p and may have a redundant function with Sco1p in delivery of copper to cytochrome c oxidase; interacts with Cox2p
Localization:
Intensity:
Fold change:
Significance:
-
C’ GFP library in SD
below threshold13.49 -
N' NOP1pr-GFP in SD

mitochondria142.974 -
N' TEF2pr-mCherry in SD

mitochondria17.2717 -
N' NATIVEpr-GFP in SD

mitochondria23.6505 -
N' TEF2pr-VC and Cyto-VN in SD

#N/A0 -
C’ GFP library in SD+DTT

cytosol13.110.97No -
C’ GFP library in SD+H2O2
cytosol14.571.08No -
C’ GFP library in Starvation Media

cytosol13.791.02No -
C’ GFP library on the background of Pup2-DaMP

below threshold -
C’ GFP library on the background of CCT mutant

below threshold16.02351.18718No
